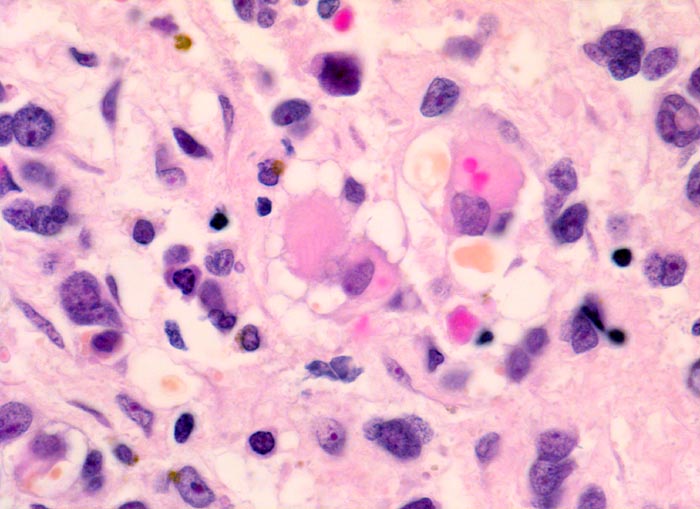

PathoPic – image database / PathoPic ID 5132 - embryonales Rhabdomyosarkom
de
Diagnose
embryonales Rhabdomyosarkom
Diagnose Gruppe
maligner Tumor
Topographie
Weichteile Kopf
Topographie Gruppe
Weichteile
Beschreibung
Klinik
Schmerzloser rasch wachsender Tumor im oberen inneren Quadranten der Orbita mit Verdrängung des Bulbus nach temporal. Diplopie.
Bilder Typ
Histologie
Vergrösserung
630
Alter
5
Geschlecht
unbekannt
Datum
Ersteintrag: 06.07.2002
Update: 04.02.2024